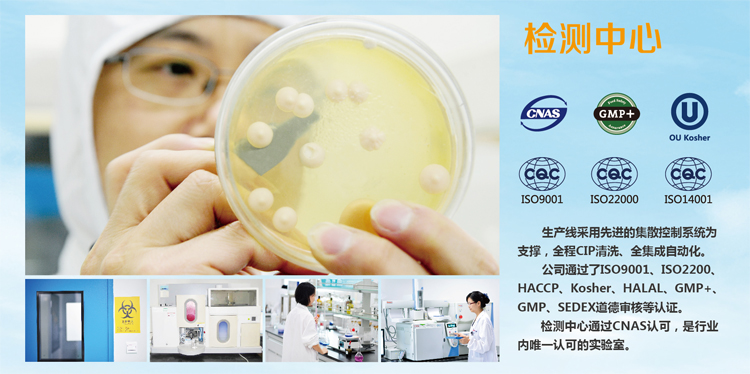
品質.jpg

【安琪酵母】邦保斯整箱購 20包/箱 10kg 提高特異性及非特異性免疫 抗應激
領券
共4張
¥10.00
¥30.00
¥70.00
¥180.00
促銷
- 豬易豆抵現豬易豆可抵現0.27元
- 銷量1215件
關閉
北京市
安徽省
福建省
甘肅省
廣東省
廣西壯族自治區
貴州省
海南省
河北省
河南省
黑龍江省
湖北省
湖南省
吉林省
江蘇省
江西省
遼寧省
內蒙古自治區
寧夏回族自治區
青海省
山東省
山西省
陜西省
上海市
四川省
天津市
西藏自治區
新疆維吾爾自治區
云南省
浙江省
重慶市
香港特別行政區
澳門特別行政區
臺灣省
正品保障 擔保交易 假一賠三 先行賠付
-
- 專家技術服務

購物咨詢(15)

欧美日韩亚洲一区二区三区在线观看
_国产在线一区二区三区_日韩在线理论_99久久99久久综合
狠狠色狠狠色综合日日tαg|
一区二区三区日韩|
蜜桃av噜噜一区|
99re热精品|
国产在线高清精品|
欧美日韩国产成人在线91|
国产精品久久久久久久久免费|
久久av一区二区|
亚洲视频在线观看|
亚洲激情在线观看视频免费|
国产亚洲成精品久久|
欧美天天综合网|
欧美激情区在线播放|
久久久久在线|
性色av香蕉一区二区|
亚洲毛片视频|
亚洲精品国久久99热|
国产亚洲成av人在线观看导航|
欧美日韩在线播放一区|
久久久久久久久久看片|
新片速递亚洲合集欧美合集|
亚洲巨乳在线|
日韩午夜视频在线观看|
亚洲精品国产欧美|
亚洲国产精品视频一区|
国产一级精品aaaaa看|
国产欧美日韩视频一区二区三区|
欧美午夜激情在线|
国产精品成人免费精品自在线观看|
欧美日韩国产一区二区|
欧美日韩不卡|
国产精品久久久久久久久久三级|
欧美欧美天天天天操|
欧美日韩精品欧美日韩精品
|
午夜国产精品影院在线观看|
亚洲天堂激情|
午夜伦欧美伦电影理论片|
亚洲午夜一区二区|
欧美在线不卡|
欧美1区2区3区|
欧美日韩亚洲一区二区三区在线|
欧美亚男人的天堂|
国产日韩欧美综合|
亚洲国产欧美日韩另类综合|
亚洲精品一区二区三|
亚洲特级毛片|
久久免费99精品久久久久久|
欧美国产乱视频|
国产精品国产精品国产专区不蜜|
国产婷婷色一区二区三区|
尤物yw午夜国产精品视频明星|
亚洲茄子视频|
午夜亚洲性色视频|
欧美成人在线免费视频|
欧美性大战xxxxx久久久|
狠狠爱www人成狠狠爱综合网|
亚洲国产精品一区在线观看不卡|
99精品欧美|
久久久亚洲欧洲日产国码αv|
欧美日韩成人综合|
伊人色综合久久天天五月婷|
99在线视频精品|
久久久久久网|
国产精品久久久久久久浪潮网站
|
亚洲一区二区三区视频|
亚洲高清一区二|
亚洲欧美成人精品|
欧美sm视频|
国产日韩精品一区|
一区二区三区高清在线|
久久久av毛片精品|
国产精品欧美久久|
日韩视频一区二区三区|
久久人人爽人人爽|
国产伦精品一区二区三区在线观看|
亚洲电影在线播放|
久久国产精品99久久久久久老狼
|
欧美激情精品|
影音欧美亚洲|
久久国产高清|
欧美午夜精品电影|
亚洲激情中文1区|
久久久久.com|
国产精品视频yy9099|
一本色道久久88亚洲综合88|
欧美成人福利视频|
国产婷婷97碰碰久久人人蜜臀|
亚洲免费在线视频一区 二区|
久久影视三级福利片|
狠狠色狠狠色综合人人|
久久不见久久见免费视频1|
国产乱码精品一区二区三区五月婷|
亚洲免费成人av|
欧美激情视频在线免费观看 欧美视频免费一|
国产日产亚洲精品|
欧美日韩综合另类|
亚洲最新在线|
国产精品v日韩精品|
亚洲在线观看|
国产日韩欧美精品综合|
久久精品视频在线免费观看|
国产一区二区中文|
久久综合伊人77777尤物|
一区二区三区自拍|
欧美mv日韩mv国产网站app|
亚洲国产日韩美|
欧美精品日本|
亚洲综合视频1区|
国产日韩高清一区二区三区在线|
久久岛国电影|
亚洲第一主播视频|
欧美日韩一区二区在线观看视频|
亚洲午夜电影|
国外成人在线|
欧美激情按摩在线|
亚洲午夜av|
精品动漫3d一区二区三区免费|
免费观看30秒视频久久|
亚洲免费电影在线观看|
国产精品揄拍500视频|
久久视频国产精品免费视频在线|
亚洲激情在线|
国产精品久久久久免费a∨|
久久精品夜夜夜夜久久|
亚洲免费观看视频|
国产欧美精品日韩精品|
久久综合色综合88|
中文亚洲字幕|
伊人天天综合|
国产精品视频第一区|
麻豆精品国产91久久久久久|
99re66热这里只有精品4|
国内外成人免费激情在线视频|
欧美好骚综合网|
久久激情网站|
亚洲图片欧洲图片日韩av|
伊人狠狠色j香婷婷综合|
国产精品乱码人人做人人爱|
美女视频黄 久久|
国产欧美日韩高清|
欧美国产日韩一区二区三区|
午夜激情亚洲|
一本久久综合亚洲鲁鲁五月天|
韩日精品中文字幕|
国产精品视频大全|
欧美人与禽猛交乱配|
久久国产一区二区|
午夜精品久久久久影视|
日韩视频在线观看|
在线观看日产精品|
国产一区久久久|
国产精品一二三|
国产精品国色综合久久|
欧美日本韩国一区|
欧美成人资源网|
久久这里有精品15一区二区三区|
亚洲欧美日韩区|
亚洲一级电影|
亚洲视屏一区|
亚洲一区二区在线免费观看|
亚洲精品一区二区网址|
亚洲激情女人|
亚洲精品国产视频|
最新国产成人av网站网址麻豆|
在线看欧美日韩|
亚洲东热激情|
亚洲精品视频免费观看|
亚洲欧洲精品一区二区三区|
亚洲福利在线视频|
久久riav二区三区|
久久久噜噜噜|
久久在线精品|
欧美刺激午夜性久久久久久久|
裸体丰满少妇做受久久99精品|
麻豆精品91|
欧美日韩亚洲高清|
欧美午夜大胆人体|
国产精品亚洲精品|
国产一区二区三区网站|
国内精品国语自产拍在线观看|
黄色国产精品|
亚洲精品女人|
午夜精品久久久久久久蜜桃app|
先锋影音国产一区|
理论片一区二区在线|
欧美精品在线观看播放|
国产精品草草|
国内精品久久久久影院薰衣草|
亚洲第一网站|
在线亚洲自拍|
久久精品欧美日韩精品|
欧美成人国产|
国产精品日韩欧美|
亚洲福利视频网|
亚洲网站在线看|
久久久蜜桃精品|
欧美日韩在线一区|
精品999久久久|
亚洲视频导航|
美玉足脚交一区二区三区图片|
好評度: 98.8%
已經是多次購買了,大品牌值得信賴,好好好好好好好。
大品牌值得信賴,已經回購多次了,質量好好好好好好好好好。